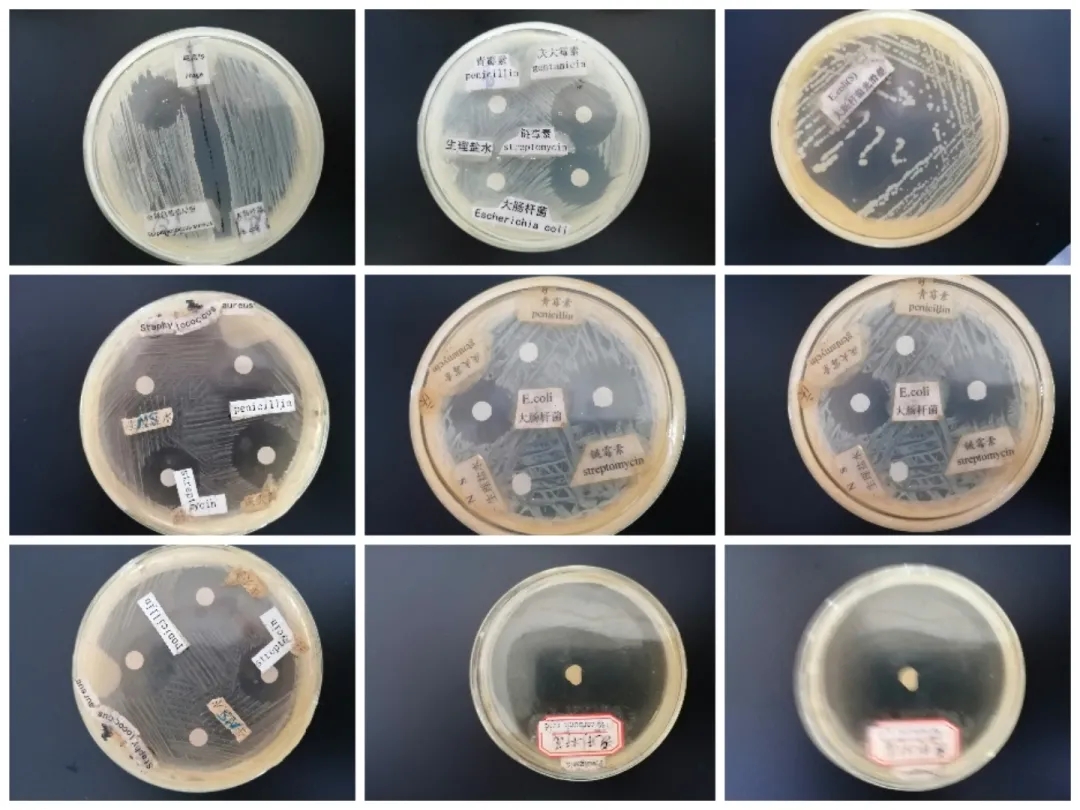
医学生学习打卡做题,医学生学习成果检验视频
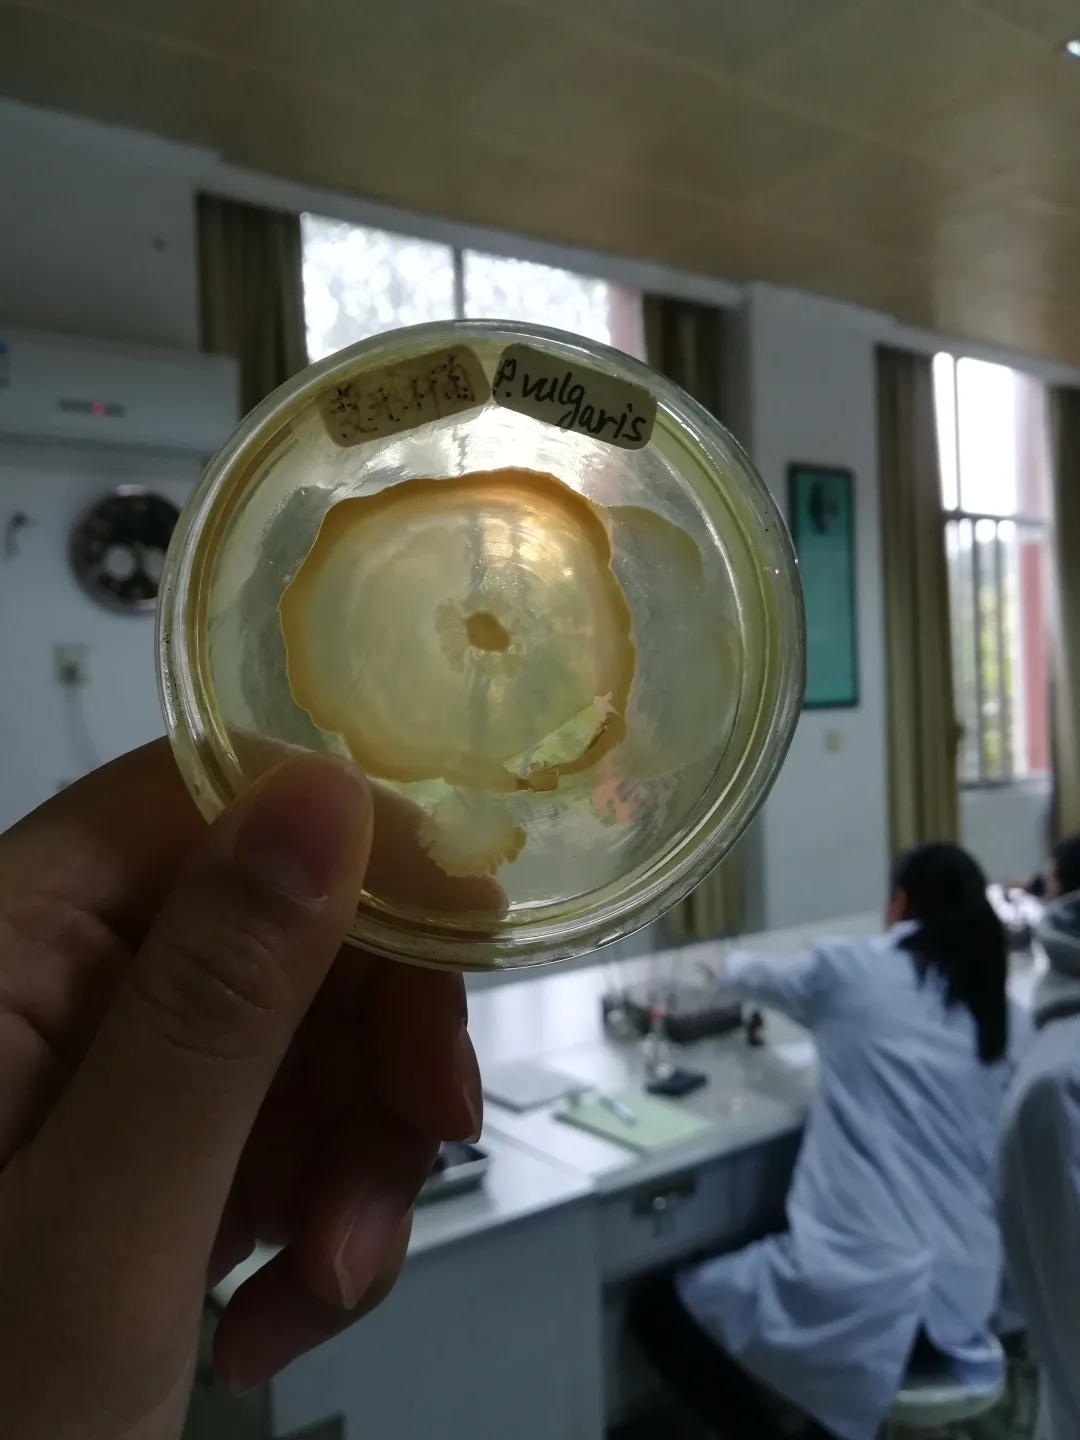
医学生学习打卡做题,医学生学习成果检验视频

当医学生被创造的时候:
一点儿体谅他人痛苦的善意
一点儿探索生命科学的博学
再来一点儿实验操作修养
......OMG......
加多啦!!!

一路积累点滴
成为一名合格的医务工作者需要经历太多考验
丰富的实验课程自然是医学生
学业生涯重要的组成部分
实验室第一课:
了解实验室相关准则
很多小伙伴都是第一次进入医学实验室
现在的温馨提示
记得码住喔
实验室安全温馨提示
- 进实验室一定穿白大褂,但白大褂不可穿出实验室。
- 食物和水不允许带入实验室。
- 严格遵守实验室药品与仪器的使用要求。
医学实验课做什么呢?
快和小编一起
走进GXMUer的实验课堂!

01 系统解剖学实验课


樱子小姐说,
“人类的头骨栖息着一只蝴蝶—‘蝶骨’。”
学习解剖,你才知道
生命有着独特的浪漫
了解人体形态学是学习医学知识的基础
打开皮肤,深入肌肉
延展血管神经,触摸脏器骨骼
我们执刀解剖人体,深指轻抚生命
尊重大体老师,是我们初次对敬畏生命的深度领悟


弄墨佳珠文苑秀
回春妙手杏林珍
回顾一下第二届基础医学绘图大赛
一起欣赏医大学子一幅幅
别具匠心的医学绘画作品吧




02 形态学实验课
不学组胚病理,你怎知道
原来细胞组织都很有想法
借一台显微镜
我们推开微观世界的大门
探究细胞组织的结构和功能
描绘显微镜下的生命色彩
每一份切片都是一篇长诗
以独特的美感讲述生命的秘密










03 机能学实验课
小白兔白又白,两只耳朵竖起来
按住大鼠,注射如玻璃纸薄的静脉
这是个和小动物们斗智斗勇的课堂
蛙心灌流
在扑通跳动的心动中领略生命的顽强
练好扎实的基础就是对生命最大的敬畏



04 医学遗传学实验课
每一条染色体都有它自己的个性
染色过后是亮眼的紫
不同类别有不一样的归属
一长串独特的基因构成独一无二的我们
学习遗传学
从源头去防止遗传病
用更科学的眼光去看待世界




05 医学微生物学实验课
还在玩“Minecraft”?
培养自己的微生物群落
打造专属培养皿
了解肉眼可视以外的奇妙世界
微生物学实验课,心动了吗?

06 医学免疫学实验课
抗原与抗体如何相爱相杀
A、B、O血型血液之间如何百团大战
欢迎来到医学生频道
“免疫学那些事儿”
带你了解生命机制里的罗曼史



07 生物化学实验课
今天的午餐怎么代谢?
生化实验课
分分钟带你拆解自己的成分
尿酮定性,酶促反应,OGTT监测血糖......
一管管药剂色彩斑驳,
生化带你从基本构成
理解生命活动的运作机制
用量精确,操作严谨
今天的你,误差零容忍了吗?





08 寄生虫实验课
你说你偏爱鱼生,囊蚴却又在其中
邂逅川卷螺溪蟹,又是一个新的开始
寄生虫,何生人
实验老师发的粪便盒子
开启一节有味道的课
用粘螨虫的胶带
探索自己身上活蹦乱跳的寄生虫
是激动还是紧张
不学习寄生虫学,
怎知道生活习惯的重要
毕竟成虫的滋味,又有谁想了解

09 诊断学实验课
哔哔—哔哔—哔哔
电子仪表勾勒的线条
书写着生命最强有力的律动
很多前辈都说,学了诊断
你就会看病了,就像个医生了
因为它会告诉你
性别/年龄/环境/遗传/都有可能是致病因素
它会教你用一般症状引出可能诊断,
借助特殊症状/体征加以辅助检查,鉴别诊断
诊断,是将基础学科串联起来的丝线
是解开患者所患何疾的钥匙
是手写大病历的开端


10 外科学实验室
学缝纫哪家强
中国医学找外科
零基础开始
肉感材料联系
教你学会单结,方结,三叠结,外科结......
还有一套柳叶刀功法等待修炼
为何操作流畅又准确?盖手熟尔




为培养高素质医学人才
强化医学生思考与操作能力
院校就基础学科、形态学、机能学等
开设丰富的实验课程
将理论应用于实践
将理论升华于实践
是医学路上的必修课



大家都穿着白大褂
光斜着照过来
光照人间
应该就是
穿着洁白的衣服的人聚在一起
不眠不休 前赴后继 托起健康的太阳



走进实验室前穿起的白大褂
像军人的钢枪
像教师的粉笔
是医学生一生形影相随的徽章
成为一名优秀的医师
要求我们认真对待每一堂实验课
积累经验,磨练技能
为从医之路打下坚实基础
来源:广西医科大学微信公众号
(图文侵删)